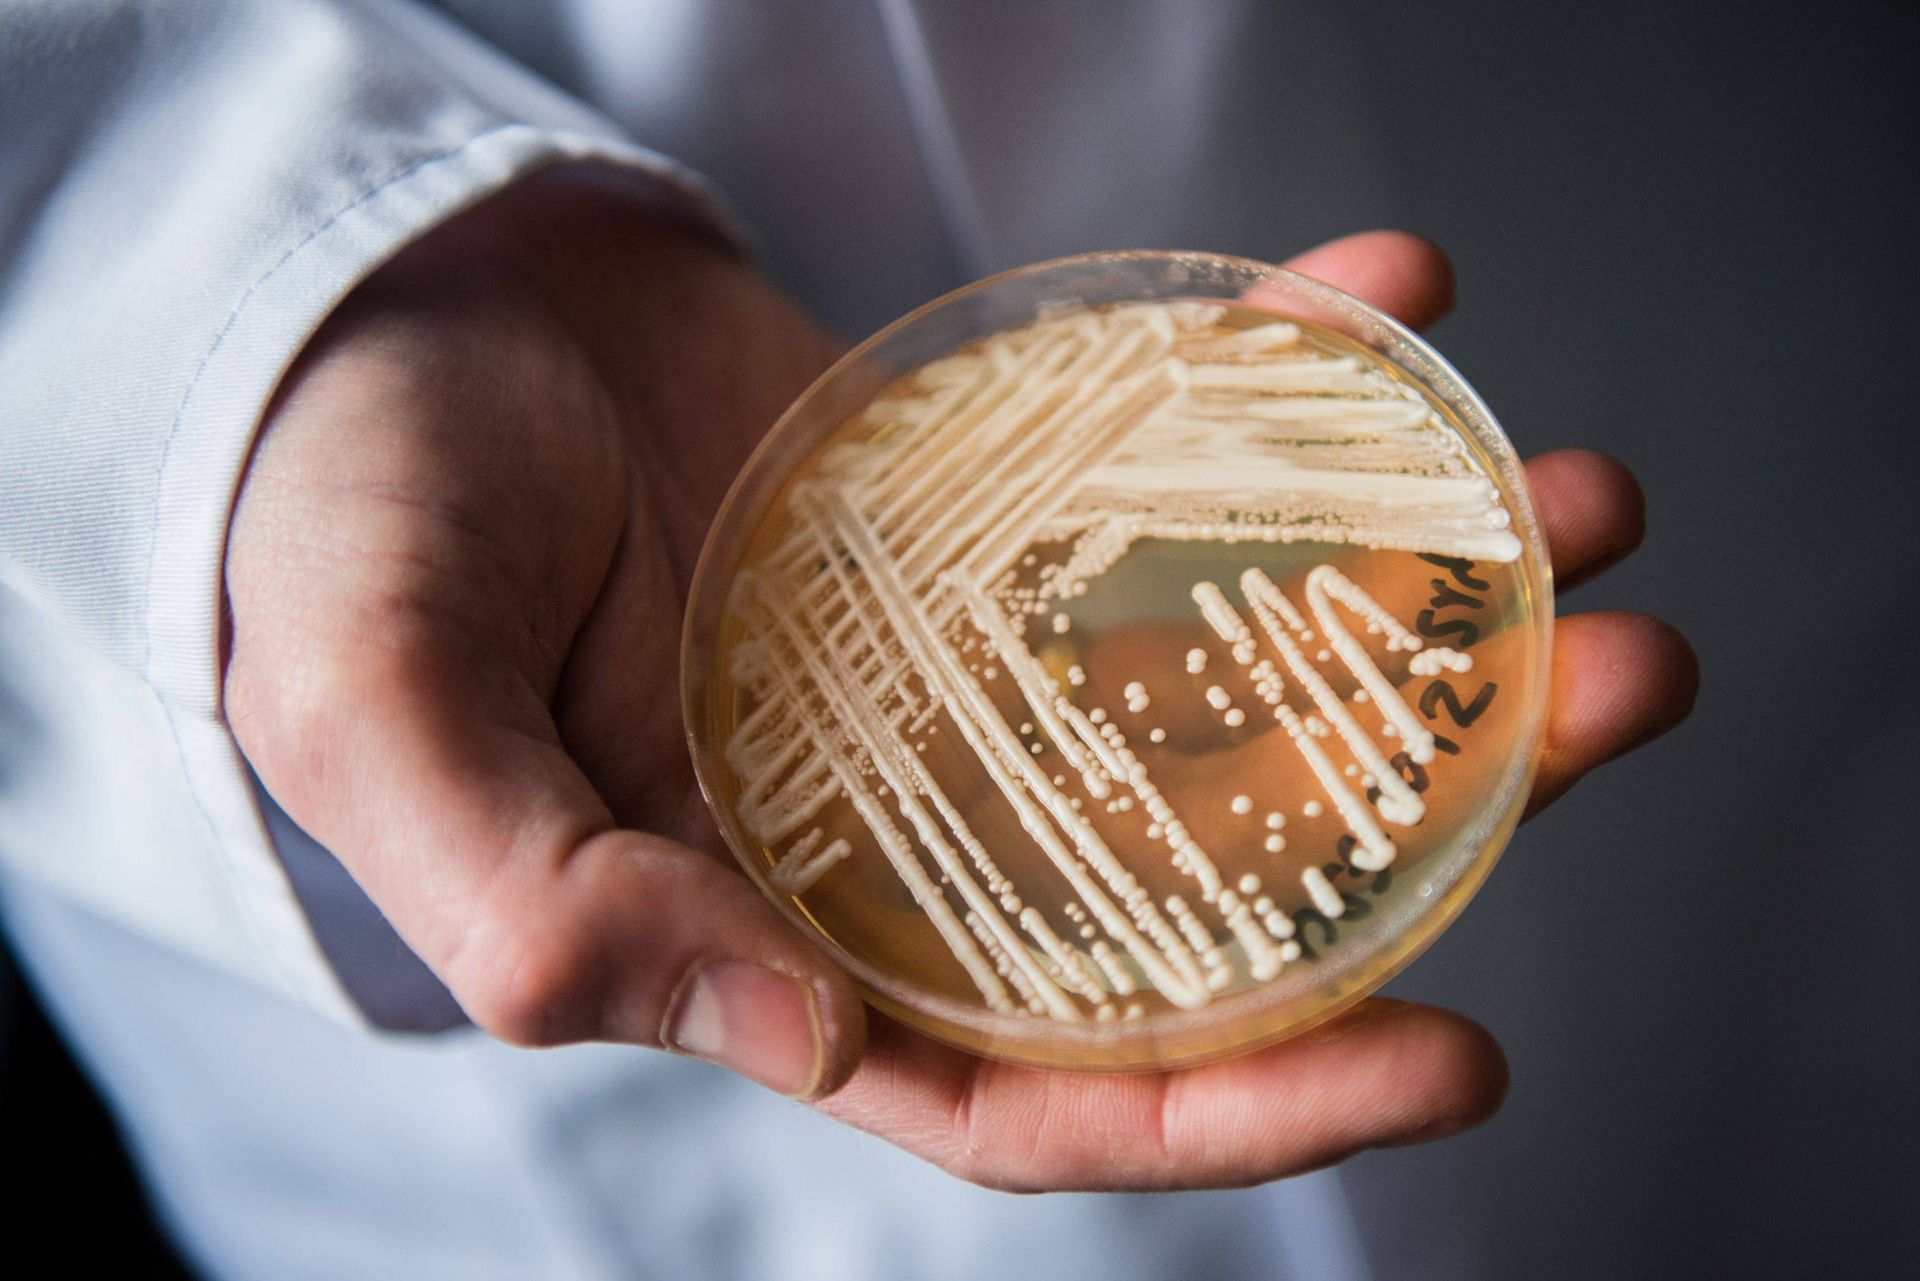
قارچ کاندیدا کشت شده در آزمایشگاه
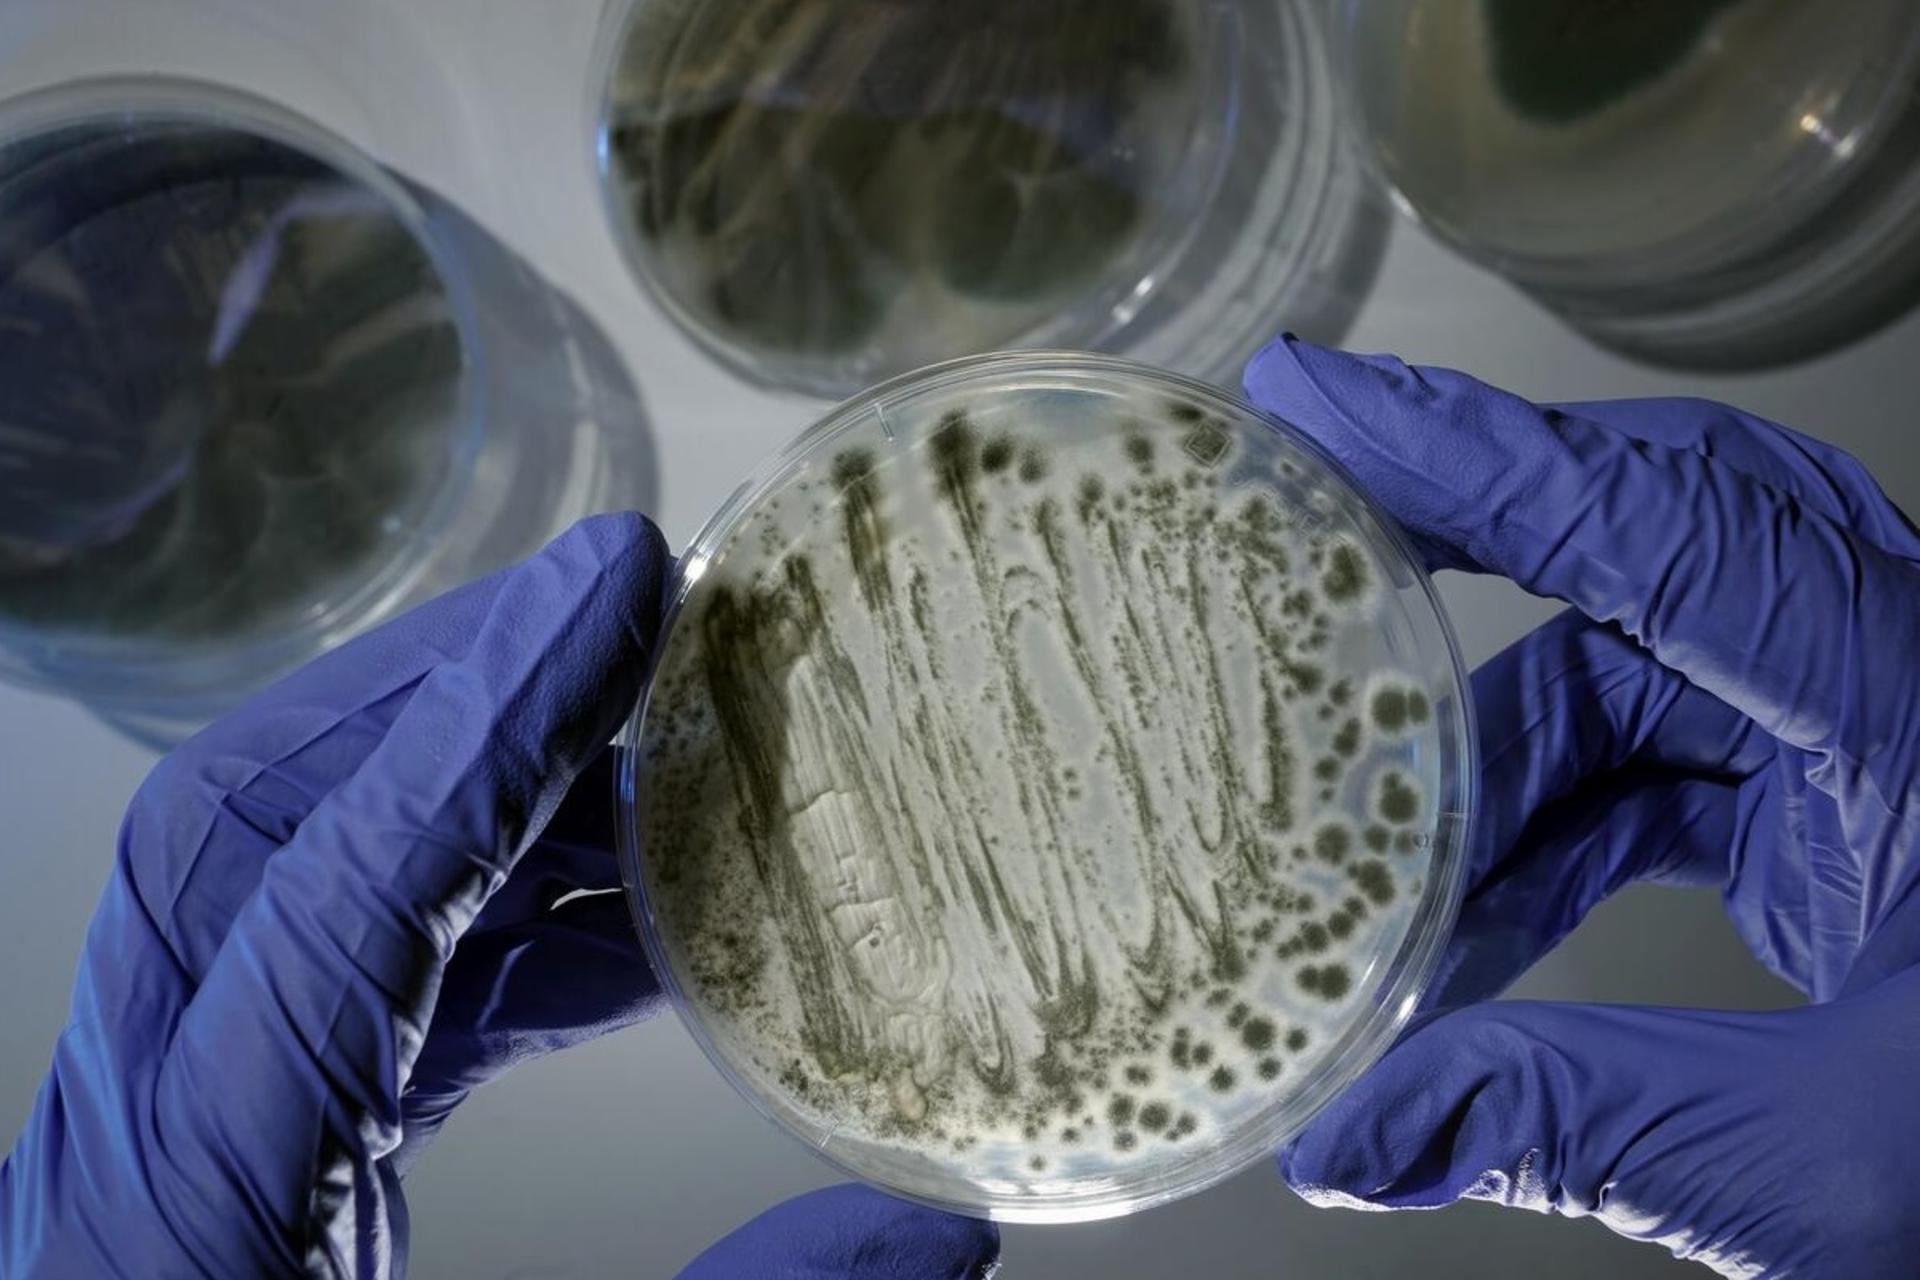
عوامل بیماری‌زای قارچی می‌توانند به‌طرز خطرناکی با گرمایش جهانی سازگار شوند

موارد ابتلا به عفونت قارچی مرگبار در آمریکا بهطرز چشمگیر در حال افزایش است
عفونتهای کاندیدا اوریس (Candida auris) برای اولینبار در سال ۲۰۱۳ در ایالات متحده شناسایی شدند. از آن زمان، هرسال تعداد افراد آلوده هرچند هنوز اندک است، افزایش چشمگیری پیدا کرده است.
در سال ۲۰۱۶، قارچ کاندیدا اوریس ۵۳ نفر را بیمار کرد. ۲۱ مارس، پژوهشگران در مجلهی Annals of Internal Medicine گزارش کردند که در سال ۲۰۲۱، این قارچ مرگبار ۱,۴۷۱ نفر را آلوده کرد که تقریباً دو برابر ۷۵۶ مورد سال قبل بود. علاوهبراین، پژوهشگران دریافتند که قارچ دربرابر داروهای ضدقارچی نیز مقاومت پیدا کرده است.
آرتورو کاسادوال، میکروبشناس و همهگیرشناس دانشکدهی پزشکی جانز هاپکینز، معتقد است که افزایش موارد و مقاومت ضدقارچی جای نگرانی دارد. وی میگوید نتایج مطالعه نیز نگرانکننده است؛ زیرا نشانگر وضعیت بدتری است که در آینده ممکن است پیش آید.
بهگزارش ساینسنیوز، پژوهشگران در آزمایشهای افراد درمعرض خطر زیاد عفونت، ۴,۰۴۱ فرد را پیدا کردند که در سال ۲۰۲۱ حامل این قارچ بودند؛ اما در آن زمان بیمار نبودند. مگان لیمن، همهگیرشناس پزشکی در شاخهی بیماریهای قارچی مرکز کنترل و پیشگیری بیماری در آتلانتا، میگوید درصد کمی از ناقلان ممکن است بعدا براثر قارچ بیمار شوند و احتمالاً به عفونتهای جریان خون گرفتار شوند که با خطر زیاد مرگ همراه است.

از سال ۲۰۱۲، عفونتهای C. auris بهطور ناگهانی در بیمارستانهای سه قاره ظاهر شد. این قارچ احتمالاً درنتیجهی تغییرات اقلیمی تکامل پیدا کرد تا بتواند در دمای بدن انسان رشد کند.
قارچ مذکور که معمولاً ازطریق آزمایشهای خون یا ادرار تشخیص داده میشود، معمولاً در مراکز مراقبتهای بهداشتی مانند بیمارستانها و مراکز توانبخشی و مراکز مراقبت طولانیمدت افراد را آلوده میکند. ازآنجاکه افرادی که آلوده میشوند اغلب از قبل بیمار هستند، تشخیص این مسئله ممکن است دشوار باشد که آیا علائمی نظیر تب از بیماری موجود یا از عفونت ناشی میشود.

افرادی که بیشتر درمعرض خطر عفونت قارچی هستند، شامل کسانی میشود که کاتتر یا لوله تنفسی یا لوله تغذیه یا سایر دستگاههای پزشکی تهاجمی به آنها متصل است و کسانی که بهطور مکرر یا بهمدت طولانی در مراکز مراقبتهای بهداشتی بهسر میبرند. لیمن میگوید افراد سالم معمولاً آلوده نیستند؛ اما میتوانند ازطریق تماس با سطوح آلوده ازجمله روپوشها و دستکشهایی که کارکنان مراقبتهای بهداشتی میپوشند، آن را به دیگران منتقل کنند.
افزایش مقاومت دارویی
عفونتهای قارچی را میتوان با استفاده از داروهای ضدقارچ درمان کرد؛ اما لیمن و همکارانش دریافتند که قارچ کاندیدا اوریس در حال مقاومشدن دربرابر گروه مهمی از داروهای ضدقارچی به نام «اکینوکاندینها» است. کاسادوال میگوید این داروها هم بهعنوان گزینه اول و هم بهعنوان گزینهی آخر برای دفاع دربرابر کاندیدا اوریس استفاده میشوند.
قبل از سال ۲۰۲۰، شش نفر شناسایی شده بودند که عفونتهای مقاوم به اکینوکاندین داشتند و چهار نفر دچار عفونتهای مقاوم به هر سه گروه از داروهای ضدقارچی موجود بودند. این مقاومت در جریان درمان با استفاده از اکینوکاندین ایجاد شده بود. هیچیک از آن موارد سویه مقاوم را به دیگران منتقل نکردند؛ اما در سال ۲۰۲۱، نوزده نفر مبتلا به عفونتهای مقاوم به اکینوکاندین تشخیص داده شدند و هفت نفر عفونتهای مقاوم به چندین دارو داشتند.
موضوع نگرانکنندهتر این است که شیوعی در واشینگتن و نیز شیوع دیگری در تگزاس نشان داد افراد میتوانند عفونتهای مقاوم به دارو را به یکدیگر منتقل کنند. لیمن میگوید: «بیمارانی که هرگز اکینوکاندین مصرف نکرده بودند، در حال آلودهشدن به سویههای مقاوم بودند.»
برخی از مراکز بهداشت و درمان توانستهاند موارد را بهموقع شناسایی و از شیوع جلوگیری کنند. لیمن میگوید: «بدیهی است که بسیار نگران هستیم؛ اما مشاهده موفقیت این مراکز در مهار آن، به ما انگیزه میدهد.» او میگوید استفاده از اقداماتی که آن مراکز برای مهار عفونت انجام دادهاند، ممکن است به محدودکردن موارد C. auris و کاهش انتشار سایر پاتوژنهای قارچی و باکتریایی و ویروسی کمک کند.